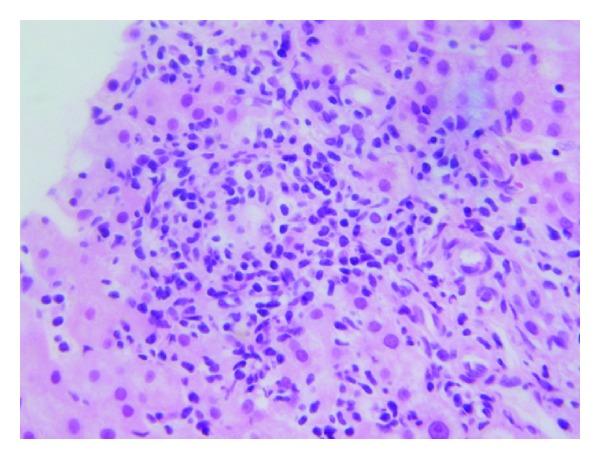

炎症性肠病中抗TNF-α治疗继发的肝损伤:病例系列及文献综述
Liver Injury Secondary to Anti-TNF-Alpha Therapy in Inflammatory Bowel Disease: A Case Series and Review of the Literature.
作者信息
Parekh Ravish, Kaur Nirmal
机构信息
Inflammatory Bowel Disease Center, Henry Ford Health System, 39450 West Twelve Mile Roud, Novi, MI 48377, USA.
出版信息
Case Rep Gastrointest Med. 2014;2014:956463. doi: 10.1155/2014/956463. Epub 2014 Jan 19.
Background. Biologic therapy to inhibit tumor necrosis factor-alpha (TNF- α ) is an effective, safe treatment for patients with inflammatory bowel disease (IBD). All TNF- α inhibitors have been associated with liver toxicity, but many of these cases have been reported in patients receiving therapy for rheumatologic disease. Herein we report the first single-center case series of TNF- α antagonist related liver injury in patients with IBD. Methods. A retrospective case series was performed at the Henry Ford Inflammatory Bowel Diseases Center. IRB approval was obtained. Results. 2 patients were treated with infliximab, whereas the 3rd patient was treated with adalimumab for IBD. All 3 patients had negative viral markers, normal autoimmune serologies, and normal biliary imaging studies. Liver biopsy was performed in all 3 patients, and evidence of portal inflammation was seen. Liver enzymes normalized after discontinuation of therapy in all patients, and no long term effects have been observed. One patient was successfully transitioned from infliximab to adalimumab without relapse of either IBD or liver injury. Conclusion. Liver injury secondary to TNF- α antagonist is an underrecognized, important clinical entity with potentially serious consequences. The mechanism of drug-induced injury is idiosyncratic. Larger cohort studies are needed to establish risk factors and injury patterns related to hepatotoxicity in these patients.
背景。抑制肿瘤坏死因子-α(TNF-α)的生物疗法是治疗炎症性肠病(IBD)患者的一种有效、安全的方法。所有TNF-α抑制剂均与肝毒性有关,但其中许多病例是在接受风湿性疾病治疗的患者中报告的。在此,我们报告了首例单中心IBD患者中与TNF-α拮抗剂相关的肝损伤病例系列。方法。在亨利福特炎症性肠病中心进行了一项回顾性病例系列研究。获得了机构审查委员会(IRB)的批准。结果。2例患者接受英夫利昔单抗治疗,而第3例患者接受阿达木单抗治疗IBD。所有3例患者病毒标志物均为阴性,自身免疫血清学正常,胆道影像学检查正常。所有3例患者均进行了肝活检,可见门静脉炎症证据。所有患者停药后肝酶均恢复正常,且未观察到长期影响。1例患者成功从英夫利昔单抗转换为阿达木单抗,IBD和肝损伤均未复发。结论。TNF-α拮抗剂继发的肝损伤是一种未被充分认识的重要临床实体,可能产生严重后果。药物性损伤的机制是特异质的。需要更大规模的队列研究来确定这些患者肝毒性的危险因素和损伤模式。